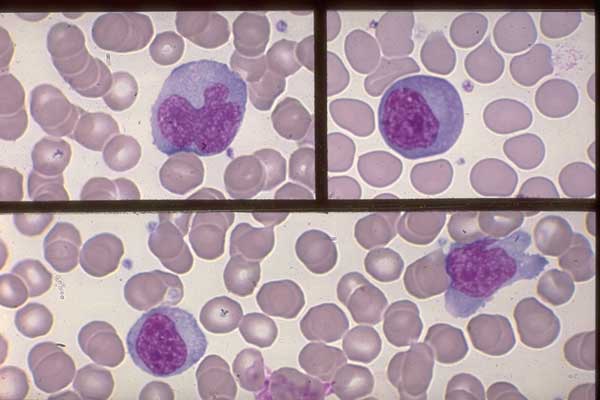
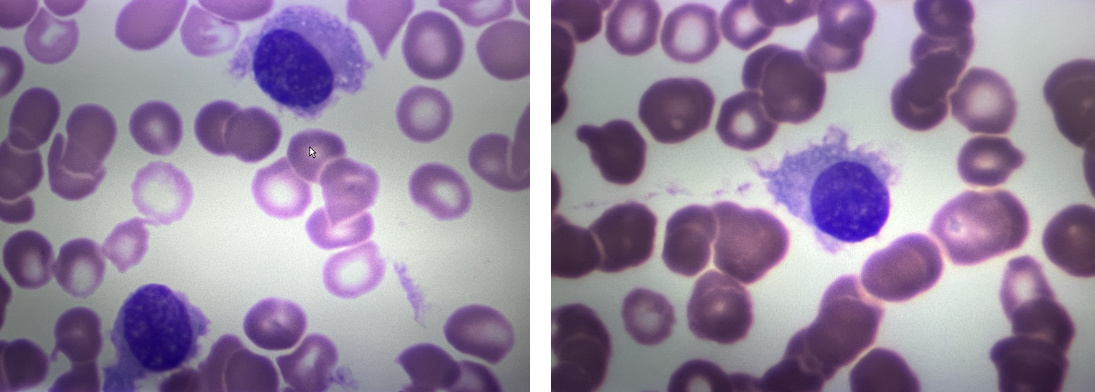

Лейкоз Кожи Фото
Лейкоз Кожи Фото 114 фото
Мода 19 Века В России Женщины Фото
Слив Фото Astasiadream Слитые
Осень Листва Картинки
Чесночно Сметанный Соус Фото Рецепт
Михаил Шемякин Фотографии
Певица Натали Фото 2026 Года
Сорта Голубой Гортензии Фото И Названия
Ргу Нефти И Газа Фото
Фото Ебли Голых Раком
Фото Цветов Спокойной Ночи